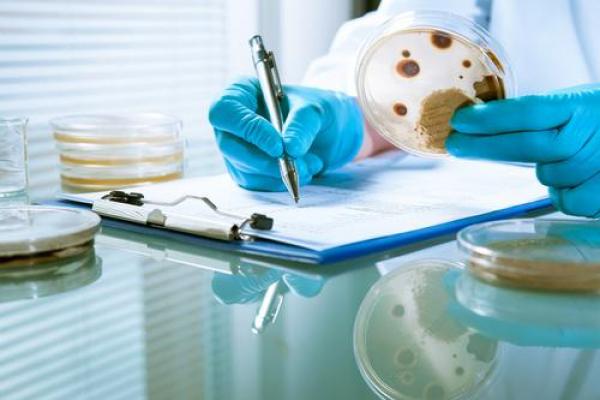

Calibración de los Equipos del Laboratorio Microbiológico
Curso
Online

¿Necesitas un coach de formación?
Te ayudará a comparar y elegir el mejor curso para ti y a financiar tu matrícula en cómodos plazos.
Diseña medidas efectivas para la calibración de equipos de laboratorio
-
Tipología
Curso
-
Metodología
Online
-
Duración
43 Días
-
Campus online
Sí
-
Servicio de consultas
Sí
-
Tutor personal
Sí
-
Clases virtuales
Sí
¿Quieres dar un paso adelante en tu carrera profesional? ¿Te gustaría aprender sobre metrologái y calibración? Si es así, Emagister te presenta este Curso en Calibración de los Equipos del Laboratorio Microbiológico, impartido por el prestigioso el centro Técnicas de Control Metrológico.
Este programa busca enseñar el proceso de calibración de equipos de laboratorio, en concreto de microbiología, para establecer qué información ofrecen los resultados y el significado de la incertidumbre y a partir de este elaborar planes de acción interna adecuados, teniendo en cuenta los requerimientos de ENAC para labotorios de microbiología.
Si estás interesado en este programa, contáctanos a través del portal educativo Emagister.com
Información importante
Documentos
- Calibracion de los equipos de laboratorio microbiologico.pdf
Bonificable:
Curso bonificable para empresas
Si eres trabajador en activo, este curso te puede salir gratis a través de tu empresa.
Instalaciones y fechas
Ubicación
Inicio
Inicio
A tener en cuenta
• Saber cómo calibrar los equipos utilizados rutinariamente en microbiología.
• Conocer el significado de la incertidumbre de calibración.
• Saber qué información ofrecen los resultados obtenidos en la calibración.
• Saber elaborar procedimientos adecuados para la calibración interna de los equipos.
• Conocer los requisitos exigidos por ENAC en relación a los equipos utilizados en los laboratorios de microbiología.
Responsables técnicos y de calidad de Laboratorios de Microbiología responsables de la gestión, control, verificación y calibración de los equipos.
Para la asistencia al curso es recomendable disponer de conocimientos sobre análisis microbiológicos.
Este curso requiere conocimientos básicos en Metrología.
Una vez finalizado el curso se le proporcionará un diploma acreditativo de la formación recibida.
Desarrollado por parte de Técnicas de Control Metrológico (TCM), entidad líder en formación en Metrología, Calidad y Productividad, con más de 20 años de experiencia en el sector.
Una vez recibida la solicitud, le enviaremos la información solicitada para su revisión y posteriormente nos pondremos en contacto contigo para confirmar que el curso cumple los objetivos que pretendes conseguir, aclarar posibles dudas...
Opiniones
-
El material recibido
← | →
Valoración del curso
Lo recomiendan
Valoración del Centro
FABIO ROBERTO DELGADO ARCENTALES
Logros de este Centro
Todos los cursos están actualizados
La valoración media es superior a 3,7
Más de 50 opiniones en los últimos 12 meses
Este centro lleva 19 años en Emagister.
Materias
- Metrología
- Estadística
- Calibración
- Verificación
- Equipos de medida
- Ensayos
- Laboratorio
- Expresión de la incertidumbre de medida
- Particularidades según la magnitud medida
- Aplicación de criterios de aceptación y rechazo
- Globalización de los resultados
- Ensayo
- Medición
- Laboratorios
- Equipo de laboratorio
- Equipos de medidad
- Patrones
- Referencias
- Trazabilidad
Temario
CONCEPTOS GENERALES
- Referencias básicas
- Medición y magnitudes
- Errores de la medición
- Resultado de la medida
- Incertidumbre de medida
- Trazabilidad de las medidas
- Calidad de las medidas
- Calibración y verificación
- Equipos de medida
- Elección de los equipos de medida
- Patrones
- Equipos en los laboratorios de microbiología
CALIBRACIÓN DE LOS EQUIPOS
- Calibración Interna
- Calibración Externa
- Cálculo de la incertidumbre de medida
- Proceso de Calibración
- Resultado de la Calibración
EQUIPOS DEL LABORATORIO MICROBIOLÓGICO
- Medios Isotermos
- Dispositivos de medición de la temperatura
- Material Volumétrico
- Peculiaridades de la Calibración de las Micropipetas
- PH - Metro
EJEMPLOS Y EJERCICIOS
- Calibración de centrífugas, estufas, material volumétrico, pipetas automáticas, balanzas...
Información adicional
Curso hasta 100% Bonificable. TCM puede realizar los trámites de la bonificación.
IN COMPANY: solicita información.
VIDEO-CONFERENCIA: todos nuestros cursos Presenciales incluyen alumnos que acceden por este medio,
ONLINE: También disponible en Modalidad Online
¿Necesitas un coach de formación?
Te ayudará a comparar y elegir el mejor curso para ti y a financiar tu matrícula en cómodos plazos.
Calibración de los Equipos del Laboratorio Microbiológico